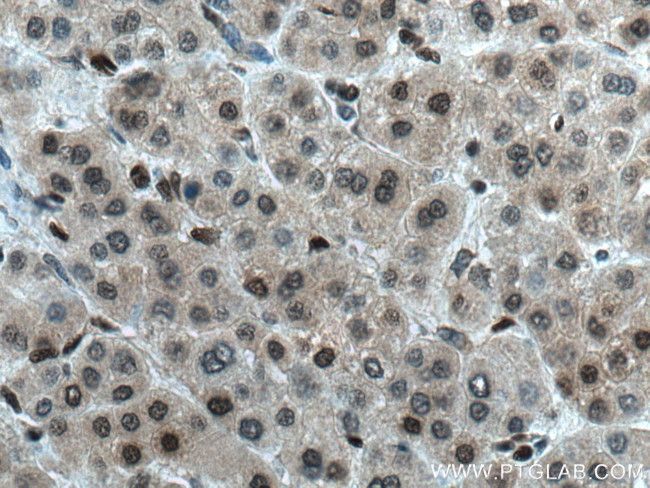
MGMT Antibody in Immunohistochemistry (Paraffin) (IHC (P))

Search
Proteintech
MGMT Polyclonal Antibody
{{$productOrderCtrl.translations['antibody.pdp.commerceCard.promotion.promotions']}}
{{$productOrderCtrl.translations['antibody.pdp.commerceCard.promotion.viewpromo']}}
{{$productOrderCtrl.translations['antibody.pdp.commerceCard.promotion.promocode']}}: {{promo.promoCode}} {{promo.promoTitle}} {{promo.promoDescription}}. {{$productOrderCtrl.translations['antibody.pdp.commerceCard.promotion.learnmore']}}
产品信息
17195-1-AP
种属反应
已发表种属
宿主/亚型
分类
类型
抗原
偶联物
形式
浓度
规格
纯化类型
保存液
内含物
保存条件
运输条件
产品详细信息
Immunogen sequence: MDKDCEMKR TTLDSPLGKL ELSGCEQGLH EIKLLGKGTS AADAVEVPAP AAVLGGPEPL MQCTAWLNAY FHQPEAIEEF PVPALHHPVF QQESFTRQVL WKLLKVVKFG EVISYQQLAA LAGNPKAARA VGGAMRGNPV PILIPCHRVV CSSGAVGNYS GGLAVKEWLL AHEGHRLGKP GLGGSSGLAG AWLKGAGATS GSPPAGRN (1-207 aa encoded by BC000824)
靶标信息
O6-Methylguanine-DNA Methyltransferase (MGMT) is an important DNA repair protein involved in tumor cell resistance to the cytostatic activity of chemotherapeutic alkylating agents. This protein is also effective in protecting normal cells against the genotoxic and carcinogenic effects of DNA alkylation. The alkylating drug resistance is caused by MGMT's ability to remove DNA alkyl groups introduced in the O6 position of guanine. MGMT is expressed in highly variable amounts, depending upon the cell and tissue type, species, and cellular growth characteristics. In addition, MGMT activity varies among groups of tumors and within a particular type of tumor.
仅用于科研。不用于诊断过程。未经明确授权不得转售。
生物信息学
蛋白别名: 6-O-methylguanine-DNA methyltransferase; 6-O-methylguanine-DNA methyltransferase (EC 2.1.1.63); Methylated-DNA--protein-cysteine methyltransferase; methylguanine-DNA methyltransferase; MGMT; O-6-methylguan; O-6-methylguanine-DNA-alkyltransferase; O6-methylguanine-DNA methyltransferase; unnamed protein product
基因别名: MGMT
UniProt ID: (Human) P16455
Entrez Gene ID: (Human) 4255